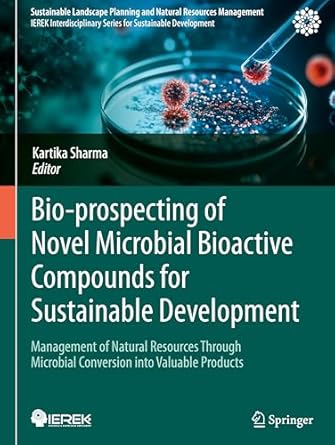
bio prospecting of novel microbial bioactive compounds for sustainable development management of natural

100 Integrals Solutions With Engineering Applications(1st Edition)
Authors:
Mehrzad Tabatabaian
Type:Hardcover/ PaperBack / Loose Leaf
Condition: Used/New
In Stock: 1 Left
Shipment time
Expected shipping within 2 - 3 DaysPopular items with books
Access to 35 Million+ Textbooks solutions
Free ✝
Ask Unlimited Questions from expert
AI-Powered Answers
30 Min Free Tutoring Session
✝ 7 days-trial
Total Price:
$0
List Price: $76.99
Savings: $76.99
(100%)
Solution Manual Includes
Access to 30 Million+ solutions
Ask 50 Questions from expert
AI-Powered Answers
24/7 Tutor Help
Detailed solutions for 100 Integrals Solutions With Engineering Applications
Price:
$9.99
/month
Book details
ISBN: B0CF3LCCTZ
Book publisher: Mercury Learning and Information
Offer Just for You!:
Buy 2 books before the end of January and enter our lucky draw.